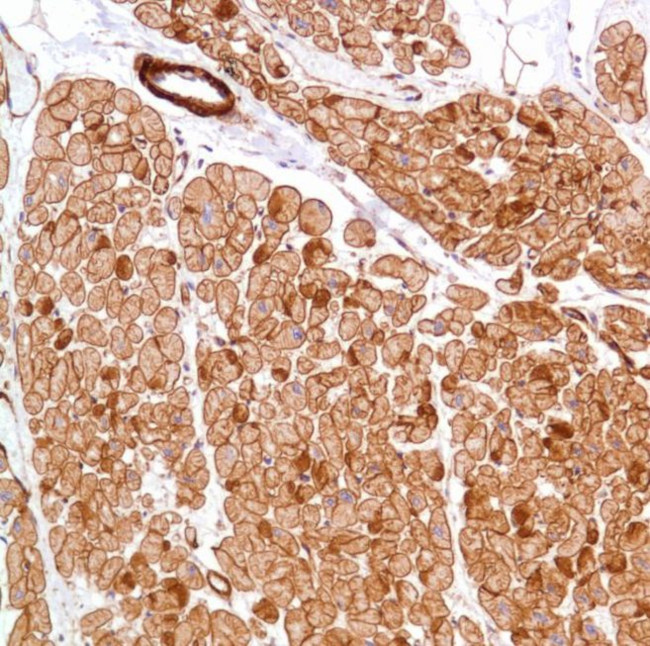
Vinculin Antibody in Immunohistochemistry (Paraffin) (IHC (P))

Search
Invitrogen
Vinculin Monoclonal Antibody (SP117)
{{$productOrderCtrl.translations['antibody.pdp.commerceCard.promotion.promotions']}}
{{$productOrderCtrl.translations['antibody.pdp.commerceCard.promotion.viewpromo']}}
{{$productOrderCtrl.translations['antibody.pdp.commerceCard.promotion.promocode']}}: {{promo.promoCode}} {{promo.promoTitle}} {{promo.promoDescription}}. {{$productOrderCtrl.translations['antibody.pdp.commerceCard.promotion.learnmore']}}

Please note: We are reviewing Western blot images included in the antibody testing data in our catalog, including those provided by third parties. Unless expressly labeled or annotated as “raw-unedited”, Western blot images included in the antibody testing data in our catalog may have been edited, optimized or otherwise adjusted for presentation.
产品信息
MA5-16424
种属反应
宿主/亚型
分类
类型
克隆号
抗原
偶联物
形式
纯化类型
保存液
内含物
保存条件
运输条件
RRID
产品详细信息
Heat-mediated antigen retrieval is recommended prior to staining, using a 10mM citrate buffer, pH 6.0, for 10 minutes followed by cooling at room temperature for 20 min. Following antigen retrieval, incubate samples with primary antibody for 10 min at room temperature. A suggested positive control is heart or small intestine tissue.
靶标信息
Vinculin (VCL) is a cytoskeletal protein associated with cell-cell and cell-extracellular matrix adherens-type junctions. It functions as one of several interacting proteins involved in anchoring F-actin to the membrane. It has been shown that a sequence of molecular interactions might be involved in the transmembrane assembly of adhesion plaques. In the assembly of adhesion plaques, the beta subunit of integrin binds to talin. Talin binds to vinculin that interacts with alpha-actinin and possibly with itself. Since alpha-actinin binds to and cross-links actin filaments, vinculin represents a key element in the transmembrane linkage of the extracellular matrix to the cytoplasmic microfilament system. Mutations in the gene can result in cardiomyopathy dilated 1W or familial hypertrophic 15.
仅用于科研。不用于诊断过程。未经明确授权不得转售。